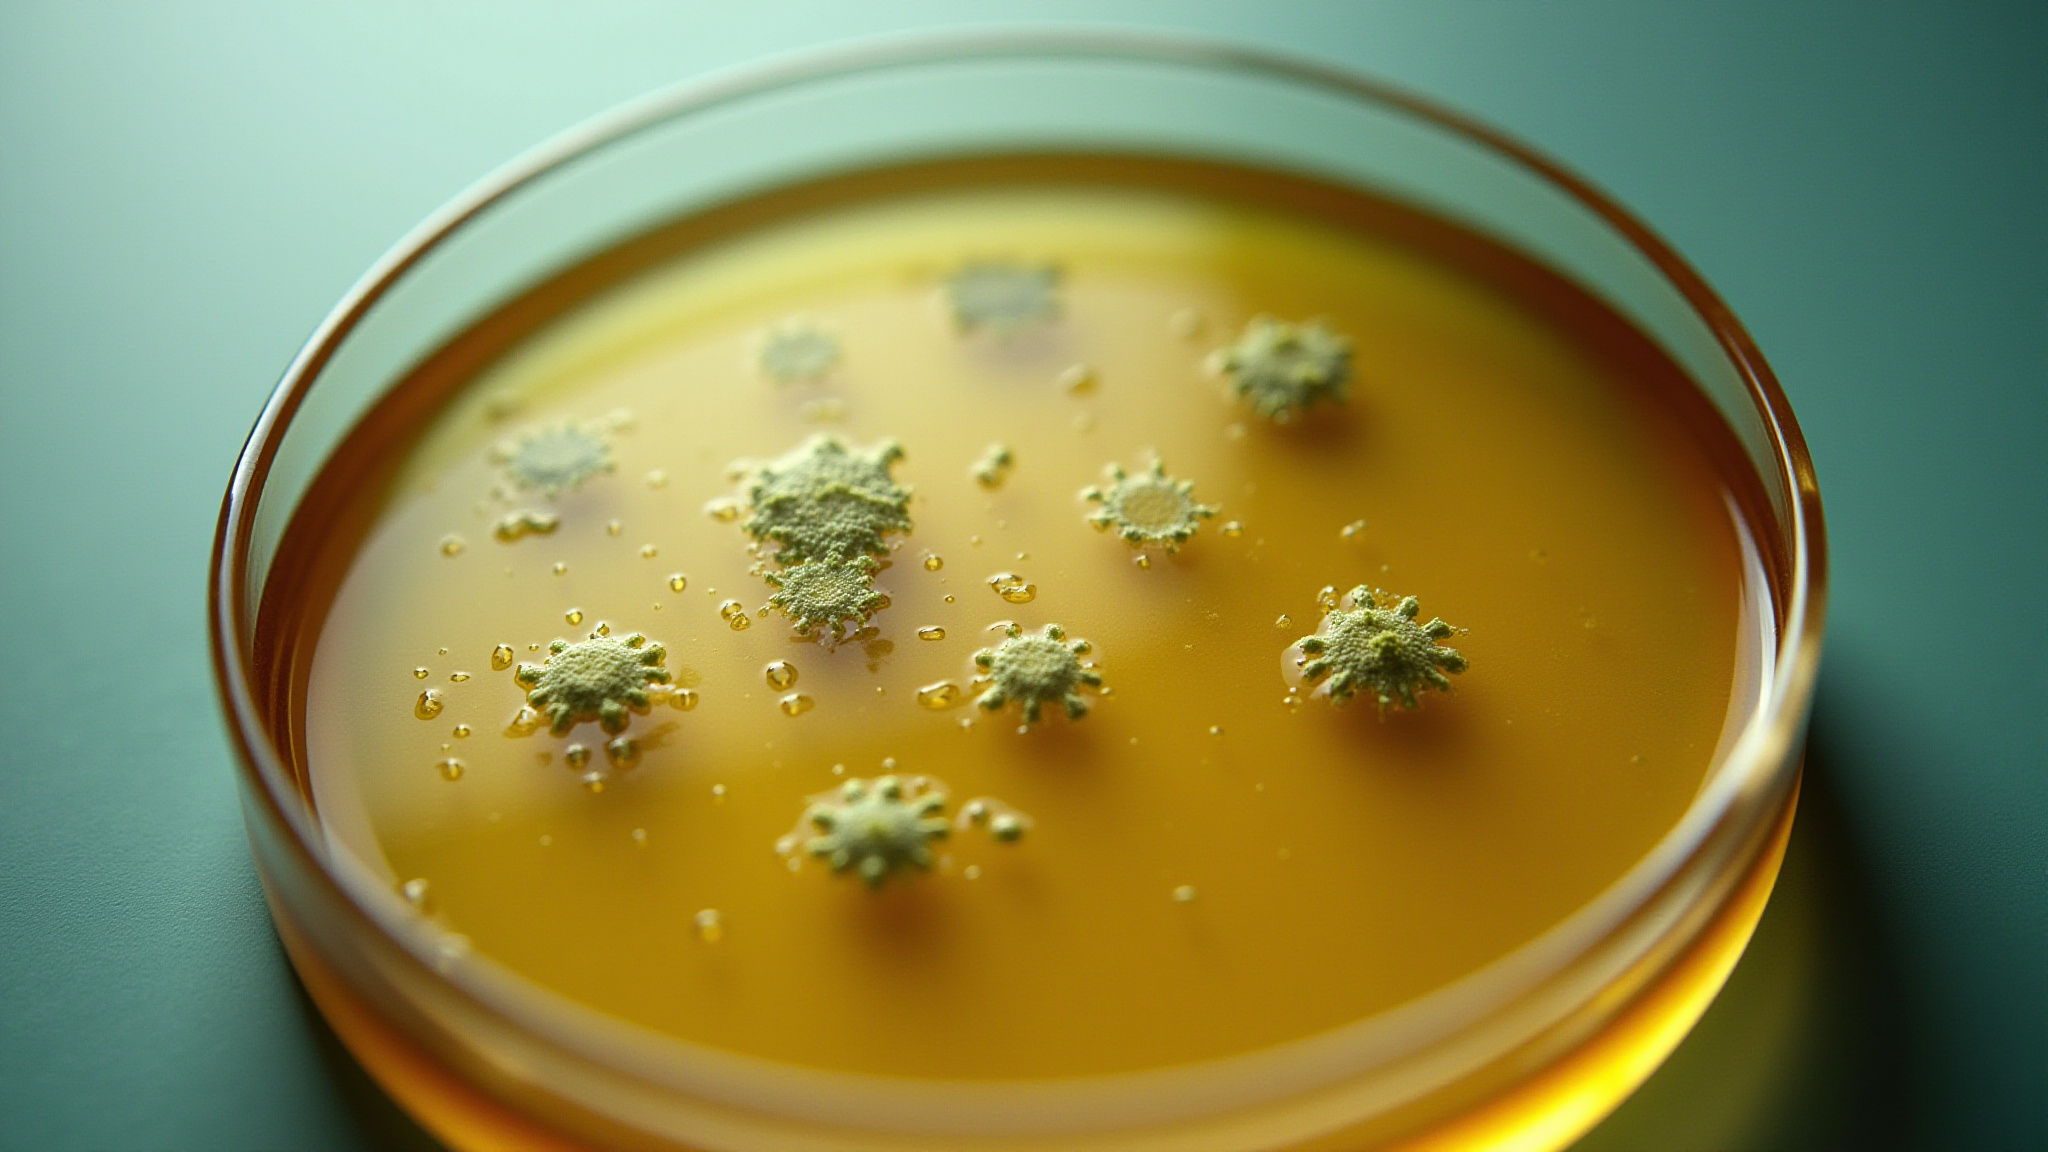

top of page

Our Focus
01
Wine and Industry Fermentation

We explore the complexities of wine fermentation techniques, also the most important molecules transformation.
02
Soil Bacteria

Our research promotes the use of beneficial bacteria to improve soil health.
03
Human Probiotics

​Tailored probiotics and prebiotics based on your microbiome to enhance human health.
bottom of page